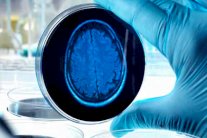
حقنة لوقف مرض الزهايمر في غضون عشر سنوات

إيلاف:& كشف باحثون أميركيون عن أن السيدات أكثر عرضة للإصابة ببروتينات خبيثة في الدماغ تزيد من خطر تعرضهن للزهايمر. كما وجد الباحثون من خلال دراسة أجروها بهذا الخصوص على 300 شخص مسن أن نسب بروتيني تاو وبيتا اميلويد الذين يسببان الحالة المرضية تقل بشكل واضح عند الرجال مقارنة بالسيدات.
وقال الباحثون إنه حين يتجمع هذين البروتينين على هيئة تشابكات أو كتل، على التوالي، فإنهما يدمران الخلايا العصبية، ما يؤدي للإصابة بفقدان في الذاكرة وتشوش.
وأوضح الباحثون في نفس السياق أن تلك البروتينات توجد في كل المادة الرمادية ولا تتسبب في حدوث مشكلة إلا عندما توجد بكميات كبيرة. ونقلت صحيفة الدايلي ميل البريطانية عن دكتور ريزا سبيرلينغ، الباحثة الرئيسية بالدراسة من مستشفى ماساتشوستس العام، قولها "تشير أدلة بحثية متزايدة إلى أن السيدات قد يكن أكثر عرضة لبعض التغييرات الفسيولوجية المرتبطة بمرض الزهايمر، وهو ما قد يسلط الضوء من جديد عن السر وراء أن اثنين من كل ثلاثة مصابين بمرض الخرف إناث".
وتابع الباحثون بتأكيدهم على تزايد أهمية التحقق من الاختلافات بين تفاصيل الذكور والإناث المتعلقة بمرض الزهايمر، وعلَّقت هنا دكتور سبيرلينغ بقولها "ويمكنني القول كذلك إن النتائج التي خلصنا إليها تدعم دراسات أخرى في تحديد الأسباب المحتملة للاختلافات المرتبطة بخطر الإصابة بالزهايمر بين الرجال والسيدات".
أعدت "إيلاف" المادة نقلاً عن صحيفة "الدايلي ميل" البريطانية، الرابط الأصلي أدناه
https://www.dailymail.co.uk/health/article-6666111/Is-women-Alzheimers-Scientists-discover-men-fewer-disease-causing-proteins.html
&
&

التعليقات